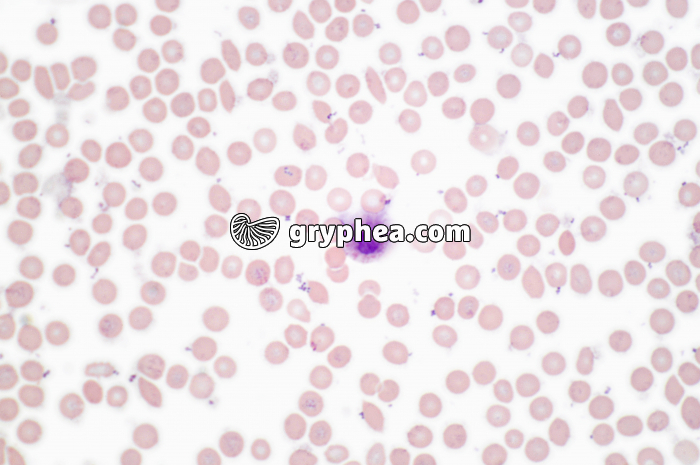
Septicémie dans sang x200 - gryphea.org

Les photographies, infographies, vidéos, sons et textes publiés sur ce site ne sont pas totalement libres de droits. Vous pouvez les utiliser librement à titre personnel, dans la création de vos cours, compte-rendus, diaporamas, en respectant le watermark qui y est inclus, à la condition expresse d'avoir souscrit à un abonnement. Le contrat d’utilisation ne vous autorise cependant pas à diffuser ces documents ailleurs que dans le cadre strict de votre enseignement, et en aucun cas sur les réseaux sociaux. Merci de votre compréhension.
Pour accéder à tous les contenus de gryphea.org, aux photos haute définition et aux vidéos intégrales, profitez de nos offres d'abonnement :
Commentaire en cours de rédaction.